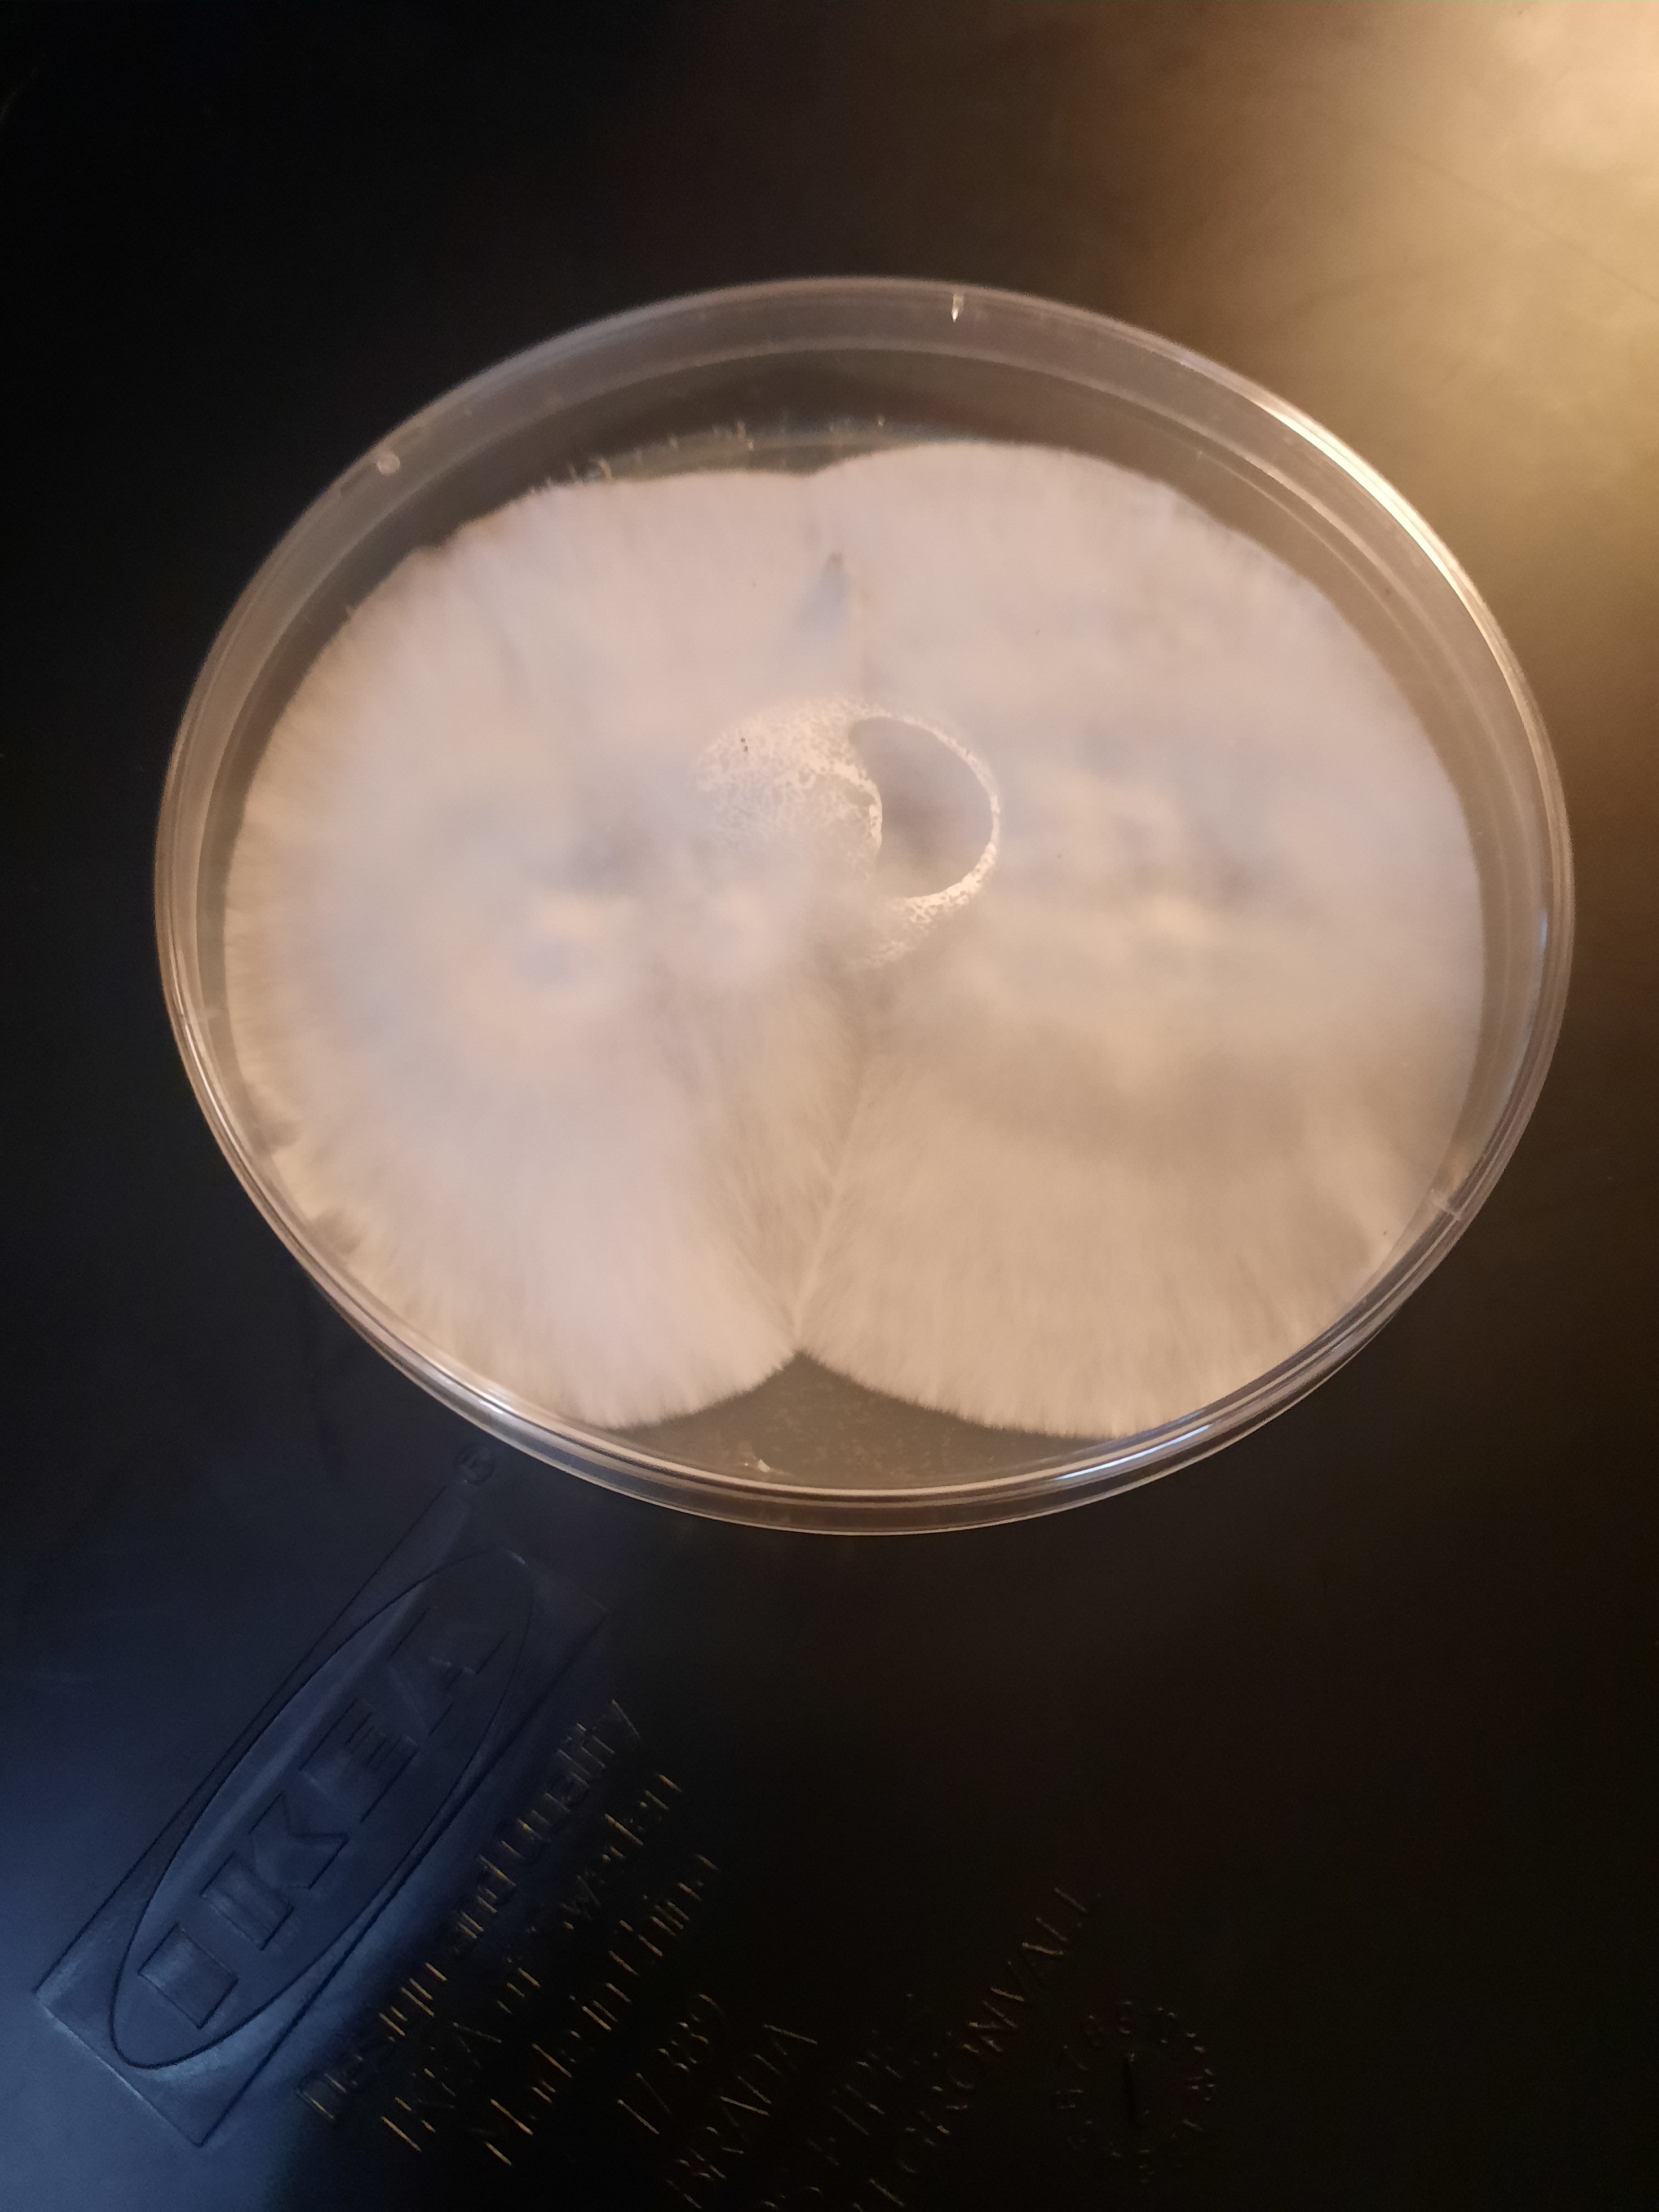
Agar TEK

The Archives
Guides to cultivation.
Showing 15 guides
Agar TEK
Using petri dishes with agar to clone mushrooms or clean up contaminated cultures, ensuring a vigorous, pure strain.
Bottle TEK
Growing mushrooms in plastic bottles, often used for species that prefer a more confined, vertical space, such as Lion’s Mane.
Broke Boi TEK
A popular, low-cost method for creating spawn using inexpensive, pre-cooked brown rice bags or brown rice in jars without a pressure cooker.
Bucket TEK
Ideal for growing oyster mushrooms on straw or wood pellets. It involves a 5-gallon bucket with holes and cold-water lime pasteurization to kill contaminants.

Grain Prep
Whole Oats or Millet. Objective: Achieve 50-55% moisture content (MC) with zero surface moisture to prevent bacterial vectoring during colonization.
Key Components of Cultivation
Learn about managing substrate, sterilization, inoculation, incubation, and fruiting conditions for successful mushroom cultivation.
Liquid Culture (LC) TEK
Creating a nutrient-rich broth to grow, store, and expand mycelium, which is then used to inoculate grain for faster colonization.
Martha Tent TEK
Using a small, humidified greenhouse tent ("Martha") with automated environmental controls for humidity and airflow to grow large quantities of mushrooms.
Monotub TEK
A popular, cost-effective method for larger-scale cultivation, using a single, large, modified plastic tub with air holes for growing. It offers good yield and space efficiency.
PF Tek (Psilocybe Fanaticus Technique)
A foundational method using substrate jars (often vermiculite and brown rice flour) that are inoculated, incubated, and then placed in a fruiting chamber.

Shoebox Tek
How to start a shoebox tek mushroom grow! This is an easy start to mushroom growing!

Still Air Box (SAB)build
Building a still air box using a tote and easy to get materials.

Substrate Preparation Protocol
Standard Operating Procedure for bulk substrate pasteurization.

Mushroom Cultivation Troubleshooting
Identify and resolve common issues with mycelial growth, fruiting stalls, and contamination.
Uncle Ben's Tek
A variation of Broke Boi Tek that uses pre-packaged microwaveable rice bags, making it extremely easy for beginners.